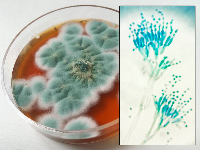
Mofo

Autoría
| Título | De microbios a plantas: misión científica |
|---|---|
| Descrición | Este REA ten como obxectivo principal fomentar no alumnado o desenvolvemento de competencias científicas e intelectuais a través dunha aprendizaxe activa, colaborativa e baseada na ciencia cidadá. Mediante a indagación sobre os reinos Monera, Protoctista, Fungos e Plantas, o alumnado identificará características, establecerá relacións, clasificará organismos, describirá procesos e buscará información de xeito autónomo. Ademais, ao participar en actividades de ciencia cidadá, implicaranse en proxectos reais de recollida e análise de datos, contribuíndo ao avance do coñecemento científico e conectando o seu traballo coa comunidade. Deste xeito, potenciaranse o pensamento crítico, a resolución de problemas e o traballo en equipo, ao mesmo tempo que se recoñece a ciencia como unha ferramenta fundamental para comprender o mundo físico-natural que nos rodea e intervir nel con creatividade e rigor. |
| Autoría |
María Jesús Fuentes Silveira Carlos de Paz Villasenín Lois Anxo Rodríguez Calvo |
| Organización |
Dirección Xeral de Ordenación e innovación Educativa Consellería de Cultura, Educación, Formación Profesional e Universidades. Xunta de Galicia. |
| Licenza | Licencia Creative Commons Reconocimiento No comercial Compartir igual 4.0 |
| Identificación |
"De microbios a plantas: misión científica" ; ISSN (web): 3101-0040 |
Este contenido creouse con eXeLearning,





































































.jpg)

.jpg)


























